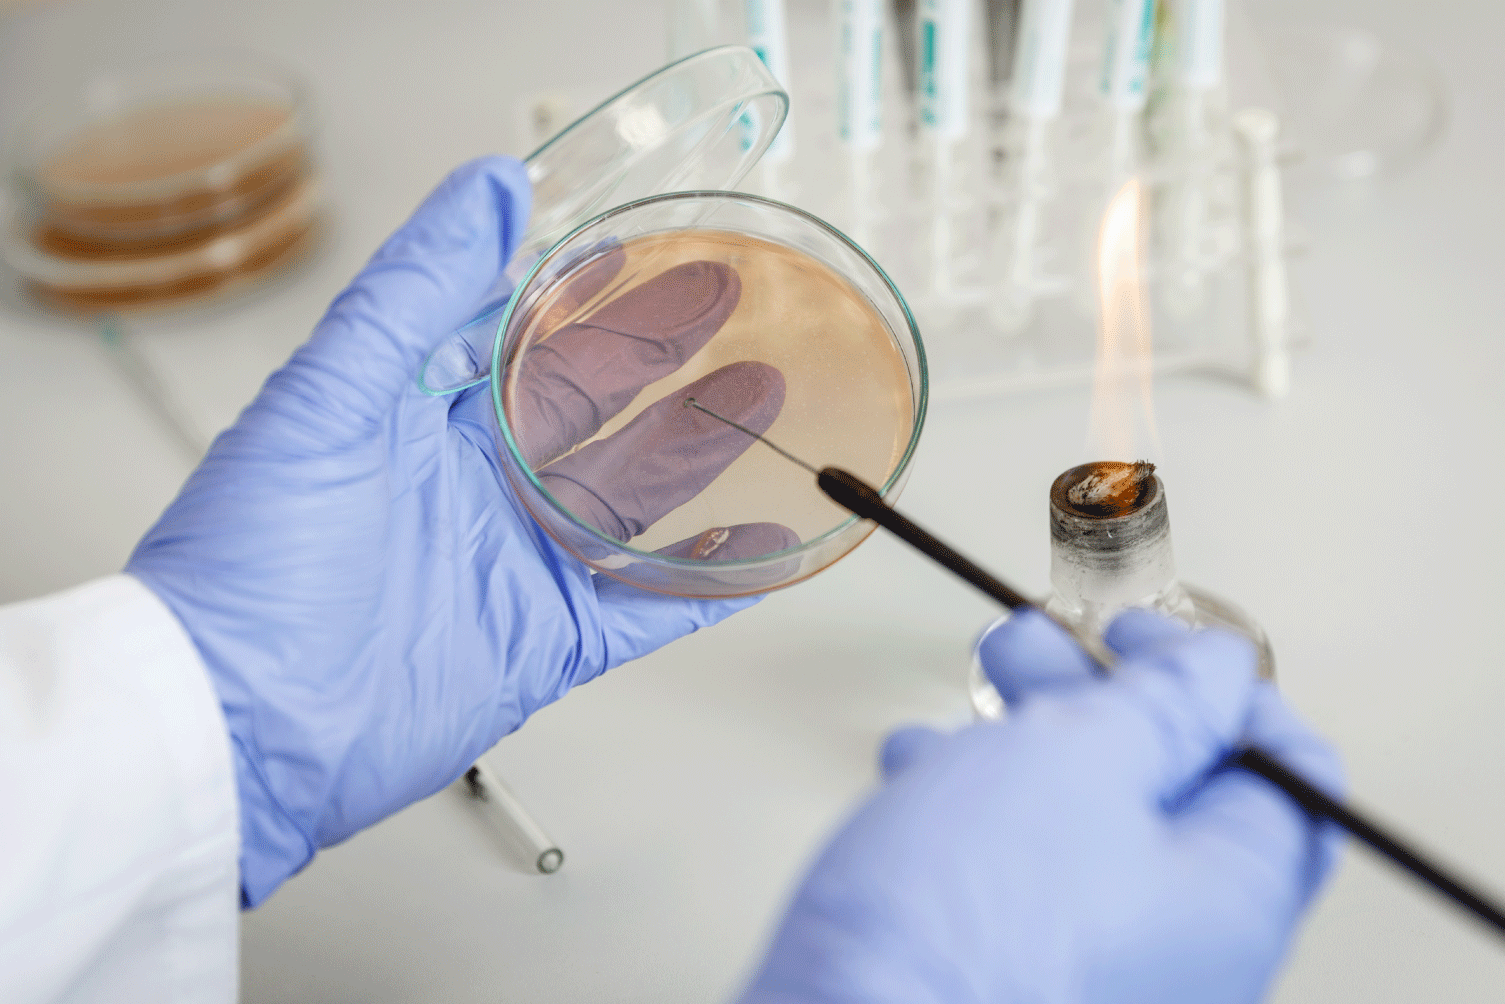

Caractérisation de substances solides
Bénéficiez d’un accompagnement personnalisé pour caractériser vos emballages, plastiques ou composts et répondre aux exigences réglementaires et environnementales.
Évaluez la biodégradabilité de vos substances, produits ou emballages dans le cadre de REACH, de la directive Biocide ou des normes sur les plastiques. Une large gamme de tests permet de vérifier la conformité réglementaire et de valoriser les performances environnementales.


Bénéficiez d’un accompagnement personnalisé pour caractériser vos emballages, plastiques ou composts et répondre aux exigences réglementaires et environnementales.

• Pour la biodégradation en compostage industriel des matières plastiques : certification selon la norme NF EN 14995.
• Pour la biodégradation en compostage industriel des emballages : certification selon la norme NF EN 13432.
• Pour la biodégradation en compostage domestique pour les plastiques : certification selon la norme NF T 51-800.
Le protocole d’essai se déroule en 4 étapes :
• Analyse de la composition de l’échantillon : vérification que les concentrations en métaux lourds ne dépassent pas les seuils de la norme NF EN 13432.
• Essai de biodégradabilité selon ISO 14855 : test de respirométrie et comparaison avec la cellulose en référence.
• Essai de désintégration selon ISO 16929 : test de l’aptitude du produit à se fragmenter sous l’effet du compostage (le seuil d’acceptabilité est qu’au moins 90% de la masse initiale passe au travers d’un tamis de mailles de 2 mm).
• Essai d’écotoxicité selon OCDE 208 : vérification de la qualité du compost par observation de la germination et de la biomasse.
Remarques :
• Les essais de biodégradabilité peuvent durer jusqu’à 6 mois et 12 mois respectivement pour les conditions de compostage industriel et domestique.
• Les essais de désintégration peuvent durer jusqu’à 12 semaines et 6 mois respectivement pour les conditions de compostage industriel et domestique.
Biodégradabilité intrinsèque évaluée selon les méthodes OCDE 302 B ou 302 C, en fonction des propriétés de la substance.

La méthode choisie dépend des propriétés physico-chimiques de la substance à analyser. Nos experts vous accompagneront pour choisir la méthode adaptée à votre besoin.
• OCDE 302 B : Essai Zahn-Wellens
• OCDE 302 C : Essai MITI modifié (II)

Biodégradabilité facile évaluée selon les méthodes OCDE 301 (A, B, D, F), choisies selon les propriétés de la substance.

La méthode choisie dépend des propriétés physico-chimiques de la substance à analyser (solubilité, volatilité, adsorbabilité).
Nos experts vous accompagneront pour choisir la méthode adaptée à votre besoin.
• OCDE 301 A : Essai de disparition du Carbone Organique Dissous
• OCDE 301 B : Essai de dégagement de dioxyde de carbone
• OCDE 301 D : Essai de flacon fermé
• OCDE 301 F : Essai de consommation d’oxygène
La biodégradabilité d’une substance organique est sa capacité à être dégradé par un processus biologique (action bactérienne), en molécules plus simples et plus petites (gaz carbonique, eau, sels minéraux).
La biodégradabilité est l’un des paramètres majeurs permettant d’évaluer l’impact environnemental de substances ou des rejets industriels.
Les essais proposés par notre laboratoire suivent des méthodes standardisées, décrites par l’OCDE. Ils permettent d’évaluer la biodégradabilité d’une substance en aérobie ou dans des conditions de compostage industrielles et domestiques.
Suivant la méthode appliquée, différents paramètres tel que le carbone organique dissout, la production de CO2 ou la consommation d’oxygène informant sur la dégradation de la substance testée sont mesurés périodiquement lors d’essai réalisés généralement sur 28 jours.
Les plastiques, les emballages et autres substances solides font l’objet d’un protocole en 4 étapes. Vous trouverez plus de détails dans l’onglet « Caractérisation de substances solides » du tableau regroupant notre offre analytique ci-dessous.
